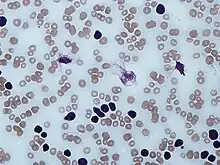

Chronic lymphocytic leukemia
| Chronic lymphocytic leukemia | |
|---|---|
| Other names: B-cell chronic lymphocytic leukemia (B-CLL)[1] | |
![]() | |
| Peripheral blood smear showing CLL cells | |
| Specialty | Hematology and oncology |
| Symptoms | Early: None[2] Later: Non-painful lymph nodes swelling, feeling tired, fever, weight loss[2] |
| Usual onset | Older than 50[3] |
| Risk factors | Family history, Agent Orange, certain insecticides[2][4] |
| Diagnostic method | Blood tests[5] |
| Differential diagnosis | Mononucleosis, hairy cell leukemia, acute lymphocytic leukemia, persistent polyclonal B-cell lymphocytosis[5] |
| Treatment | Watchful waiting, chemotherapy, immunotherapy[4][5] |
| Prognosis | Five-year survival ~83% (US)[3] |
| Frequency | 904,000 (2015)[6] |
| Deaths | 60,700 (2015)[7] |
Chronic lymphocytic leukemia (CLL) is a type of cancer in which the bone marrow makes too many lymphocytes (a type of white blood cell).[2][8] Early on there are typically no symptoms.[2] Later non-painful lymph node swelling, feeling tired, fever, night sweats, or weight loss for no clear reason may occur.[2][9] Enlargement of the spleen and low red blood cells (anemia) may also occur.[2][4] It typically worsens gradually over years.[2]
Risk factors include having a family history of the disease.[2] Exposure to Agent Orange and certain insecticides might also be a risk.[4] CLL results in the buildup of B cell lymphocytes in the bone marrow, lymph nodes, and blood.[4] These cells do not function well and crowd out healthy blood cells.[2] CLL is divided into two main types: those with a mutated IGHV gene and those without.[4] Diagnosis is typically based on blood tests finding high numbers of mature lymphocytes and smudge cells.[5]
Management of early disease is generally with watchful waiting.[5] Infections should more readily be treated with antibiotics.[4] In those with significant symptoms, chemotherapy or immunotherapy may be used.[4] As of 2019 ibrutinib is often the initial medication recommended.[10] The medications fludarabine, cyclophosphamide, and rituximab were previously the initial treatment in those who are otherwise healthy.[11]
CLL affected about 904,000 people globally in 2015 and resulted in 60,700 deaths.[6][7] The disease most commonly occurs in people over the age of 50.[3] Males are affected more often than females.[3] It is much less common in people from Asia.[4] Five-year survival following diagnosis is approximately 83% in the United States.[3] It represents less than 1% of deaths from cancer.[7]
Signs and symptoms

Most people are diagnosed as having CLL based on the result of a routine blood test that shows a high white blood cell count, specifically a large increase in the number of circulating lymphocytes.[9] These people generally have no symptoms.[9] Less commonly, CLL may present with enlarged lymph nodes.[9] This is referred to as small lymphocytic lymphoma. Less commonly the disease comes to light only after the cancerous cells overwhelm the bone marrow resulting in low red blood cells, neutrophils, or platelets.[9] Or there is fever, night sweats, weight loss, and the person feels tired.[9]
CLL is, in virtually all cases, preceded by a particular subtype of monoclonal B-cell lymphocytosis (MBL). This subtype, termed chronic lymphocytic leukemia/small lymphocyte lymphoma MBL (CLL/SLL MBL) is an asymptomatic, indolent, and chronic disorder in which individuals exhibit an increase in the number of circulating B-cell lymphocytes. These B-cells are abnormal: they are monoclonal, i.e. produced by a single ancestral B-cell, and have some of the same cell marker proteins, chromosome abnormalities, and gene mutations found in CLL.[12][13] CLL/SLL MBL consist of two groups: low-count CLL/SLL MBL has monoclonal B-cell blood counts of <0.5x9 cells/liter (i.e. 0.5x9/L) while high-count CLL/SLL MBL has blood monoclonal B-cell counts ≥0.5x9/L but <5x109/L.[14] Individuals with blood counts of these monoclonal B-cells >5x9/L are diagnosed as having CLL. Low-count CLL/SLLL MBL rarely if ever progresses to CLL while high-count CLL/SLL MBL does so at a rate of 1-2% per year. Thus, CLL may present in individuals with a long history of having high-count CLL/SLL MBL. There is no established treatment for these individuals except monitoring for development of the disorder's various complications (see treatment of MBL complications) and for their progression to CLL.[15][16]
Complications
Complications include a low level of antibodies in the bloodstream (hypogammaglobulinemia) leading to recurrent infection, warm autoimmune hemolytic anemia in 10–15% of patients, and bone marrow failure. Chronic lymphocytic leukemia may also transform into Richter's syndrome, the development of fast-growing diffuse large B cell lymphoma, prolymphocytic leukemia, Hodgkin's lymphoma, or acute leukemia in some patients. Its incidence is estimated to be around 5% in patients with CLL.[17]
Gastrointestinal (GI) involvement can rarely occur with chronic lymphocytic leukemia. Some of the reported manifestations include intussusception, small intestinal bacterial contamination, colitis, and others. Usually, GI complications with CLL occur after Richter transformation. Two cases to date have been reported of GI involvement in chronic lymphocytic leukemia without Richter's transformation.[18]
Cause
CLL is caused by multiple genetic mutations and epigenetic changes. Men are about twice as likely to get CLL as women, and risk increases with age.[19] It is relatively rare among Asians. Some relevant genetic mutations may be inherited; in around 9% of CLL cases a parent had CLL. Exposure to Agent Orange increases the risk of CLL, and exposure to hepatitis C virus may increase the risk.[19] There is no clear association between ionizing radiation exposure and the risk of developing CLL.[19] Blood transfusions have been ruled out as a risk factor.[20]
Diagnosis

CLL is usually first suspected by a diagnosis of lymphocytosis, an increase in a type of white blood cell, on a complete blood count test. This frequently is an incidental finding on a routine physician visit. The lymphocyte count is greater than 5,000 cells per microliter (µl) of blood.[11] The presence of lymphocytosis in an elderly individual should raise strong suspicion for CLL, and a confirmatory diagnostic test, in particular flow cytometry, should be performed unless clinically unnecessary.
A peripheral blood smear showing an abundance of damaged cells known as "smudge cells" or "basket cells" can also indicate the presence of the disease (smudge cells are due to cancer cells lacking in vimentin, a cytoskeletal protein).[21]: 1899
The diagnosis of CLL is based on the demonstration of an abnormal population of B lymphocytes in the blood, bone marrow, or tissues that display an unusual but characteristic pattern of molecules on the cell surface. This atypical molecular pattern includes the coexpression of cell surface markers clusters of differentiation 5 (CD5) and 23. In addition, all the CLL cells within one individual are clonal, that is, genetically identical. In practice, this is inferred by the detection of only one of the mutually exclusive antibody light chains, kappa or lambda, on the entire population of the abnormal B cells. Normal B lymphocytes consist of a stew of different antibody-producing cells, resulting in a mixture of both kappa- and lambda-expressing cells. The lack of the normal distribution of these B cells is one basis for demonstrating clonality, the key element for establishing a diagnosis of any B cell malignancy (B cell non-Hodgkin lymphoma).
The combination of the microscopic examination of the peripheral blood and analysis of the lymphocytes by flow cytometry to confirm clonality and marker molecule expression is needed to establish the diagnosis of CLL. Both are easily accomplished on a small amount of blood. A flow cytometer instrument can examine the expression of molecules on individual cells in fluids. This requires the use of specific antibodies to marker molecules with fluorescent tags recognized by the instrument. In CLL, the lymphocytes are genetically clonal, of the B cell lineage (expressing marker molecules clusters of differentiation 19 and 20), and characteristically express the marker molecules CD5 and CD23. These B cells resemble normal lymphocytes under the microscope, although slightly smaller, and are fragile when smeared onto a glass slide, giving rise to many broken cells, which are called "smudge" or "smear" cells.[22]
The Matutes's CLL score allows the identification of a homogeneous subgroup of classical CLL, that differs from atypical/mixed CLL for the five markers' expression (CD5, CD23, FMC7, CD22, and immunoglobulin light chain) Matutes's CLL scoring system is very helpful for the differential diagnosis between classical CLL and the other B cell chronic lymphoproliferative disorders, but not for the immunological distinction between mixed/atypical CLL and mantle cell lymphoma (MCL malignant B cells).[23] Discrimination between CLL and MCL can be improved by adding non-routine markers such as CD54[24] and CD200.[25] Among routine markers, the most discriminating feature is the CD20/CD23 mean fluorescence intensity ratio. In contrast, FMC7 expression can surprisingly be misleading for borderline cases.[26]
Clinical staging
Staging, determining the extent of the disease, is done with the Rai staging system or the Binet classification (see details[27]) and is based primarily on the presence of a low platelet or red cell count. Early-stage disease does not need to be treated. CLL and SLL are considered the same underlying disease, just with different appearances.[28]: 1441
- Stage 0: characterized by absolute lymphocytosis (>15,000/mm3) without lymphadenopathy, hepatosplenomegaly, anemia, or thrombocytopenia
- Stage I: characterized by absolute lymphocytosis with lymphadenopathy without hepatosplenomegaly, anemia, or thrombocytopenia
- Stage II: characterized by absolute lymphocytosis with either hepatomegaly or splenomegaly with or without lymphadenopathy
- Stage III: characterized by absolute lymphocytosis and anemia (hemoglobin <11 g/dL) with or without lymphadenopathy, hepatomegaly, or splenomegaly
- Stage IV: characterized by absolute lymphocytosis and thrombocytopenia (<100,000/mm3) with or without lymphadenopathy, hepatomegaly, splenomegaly, or anemia
Binet classification[31]
- Clinical stage A: characterized by no anemia or thrombocytopenia and fewer than three areas of lymphoid involvement (Rai stages 0, I, and II)
- Clinical stage B: characterized by no anemia or thrombocytopenia with three or more areas of lymphoid involvement (Rai stages I and II)
- Clinical stage C: characterized by anemia and/or thrombocytopenia regardless of the number of areas of lymphoid enlargement (Rai stages III and IV)
Array-based karyotyping
Array-based karyotyping is a cost-effective alternative to FISH for detecting chromosomal abnormalities in CLL. Several clinical validation studies have shown >95% concordance with the standard CLL FISH panel.[32][33][34][35][36]
Related diseases
In the past, cases with similar microscopic appearance in the blood but with a T cell phenotype were referred to as T-cell CLL. However, these are now recognized as a separate disease group and are currently classified as T-cell prolymphocytic leukemias.[37][38]
CLL should not be confused with acute lymphoblastic leukemia, a highly aggressive leukemia most commonly diagnosed in children, and highly treatable in the pediatric setting.
Differential diagnosis
| Lymphoid disorders that can present as chronic leukemia and can be confused with typical B-cell chronic lymphoid leukemia[39] |
|---|
| Follicular lymphoma |
| Splenic marginal zone lymphoma |
| Nodal marginal zone B cell lymphoma |
| Mantle cell lymphoma |
| Hairy cell leukemia |
| Prolymphocytic leukemia (B cell or T cell) |
| Lymphoplasmacytic lymphoma |
| Sézary syndrome |
| Smoldering adult T cell leukemia/lymphoma |
Hematologic disorders that may resemble CLL in their clinical presentation, behavior, and microscopic appearance include mantle cell lymphoma, marginal zone lymphoma, B cell prolymphocytic leukemia, and lymphoplasmacytic lymphoma.
- B cell prolymphocytic leukemia, a related, but more aggressive disorder, has cells with similar phenotype, but are significantly larger than normal lymphocytes and have a prominent nucleolus. The distinction is important as the prognosis and therapy differ from CLL.
- Hairy cell leukemia is also a neoplasm of B lymphocytes, but the neoplastic cells have a distinct morphology under the microscope (hairy cell leukemia cells have delicate, hair-like projections on their surfaces) and unique marker molecule expression.
All the B cell malignancies of the blood and bone marrow can be differentiated from one another by the combination of cellular microscopic morphology, marker molecule expression, and specific tumor-associated gene defects. This is best accomplished by evaluation of the patient's blood, bone marrow, and occasionally lymph node cells by a pathologist with specific training in blood disorders. A flow cytometer is necessary for cell marker analysis, and the detection of genetic problems in the cells may require visualizing the DNA changes with fluorescent probes by FISH.
Treatment
CLL treatment focuses on controlling the disease and its symptoms rather than on an outright cure. In those without or only minimal symptoms watchful waiting is generally appropriate.[10]
CLL is treated by chemotherapy, radiation therapy, biological therapy, or bone marrow transplantation. Symptoms are sometimes treated surgically (splenectomy – removal of enlarged spleen) or by radiation therapy ("de-bulking" swollen lymph nodes).
Initial CLL treatments vary depending on the exact diagnosis and the progression of the disease, and even with the preference and experience of the health care practitioner. Any of dozens of agents may be used for CLL therapy.[40]
Decision to treat
While it is generally considered incurable, CLL progresses slowly in most cases. Many people with CLL lead normal and active lives for many years—in some cases for decades. Because of its slow onset, early-stage CLL is, in general, not treated since it is believed that early CLL intervention does not improve survival time or quality of life. Instead, the condition is monitored over time to detect any change in the disease pattern.[10][41]
The decision to start CLL treatment is taken when the person's symptoms or blood counts indicate that the disease has progressed to a point where it may affect quality of life.
Clinical "staging systems" such as the Rai four-stage system and the Binet classification can help to determine when and how to treat the patient.[27]
Determining when to start treatment and by what means is often difficult; no survival advantage is seen in treating the disease very early. The National Cancer Institute Working Group has issued guidelines for treatment, with specific markers that should be met before it is initiated.[42]
Chemotherapy
Combination chemotherapy regimens are effective in both newly diagnosed and relapsed CLL. Combinations of fludarabine with alkylating agents (cyclophosphamide) produce higher response rates and a longer progression-free survival than single agents:
- FC (fludarabine with cyclophosphamide)[43]
- FR (fludarabine with rituximab)[44]
- FCR (fludarabine, cyclophosphamide, and rituximab)[45]
- CHOP (cyclophosphamide, doxorubicin, vincristine, and prednisolone)
Although the purine analogue fludarabine was shown to give superior response rates to chlorambucil as primary therapy,[46][47] no evidence shows early use of fludarabine improves overall survival, and some clinicians prefer to reserve fludarabine for relapsed disease.
Chemoimmunotherapy with FCR has shown to improve response rates, progression-free survival, and overall survival in a large randomized trial in CLL patients selected for good physical fitness.[48] This has been the first clinical trial demonstrating that the choice of a first-line therapy can improve the overall survival of patients with CLL.
Alkylating agents approved for CLL include bendamustine and cyclophosphamide.
Targeted therapy
Targeted therapy attacks cancer cells at a specific target, with the aim of not harming normal cells. Targeted drugs used in CLL include venetoclax (a Bcl-2 inhibitor), ibrutinib (a Bruton's tyrosine kinase inhibitor), idelalisib and duvelisib (inhibitors of some forms of the enzyme phosphoinositide 3-kinase), as well as monoclonal antibodies against CD20 (rituximab, ofatumumab and obinutuzumab) and CD52 (alemtuzumab).[10][49]
Stem cell transplantation
Autologous stem cell transplantation, using the recipient's own cells, is not curative.[28]: 1458 Younger individuals, if at high risk for dying from CLL, may consider allogeneic hematopoietic stem cell transplantation (HSCT). Myeloablative (bone marrow killing) forms of allogeneic stem cell transplantation, a high-risk treatment using blood cells from a healthy donor, may be curative, but treatment-related toxicity is significant.[28]: 1458 An intermediate level, called reduced-intensity conditioning allogeneic stem cell transplantation, may be better tolerated by older or frail patients.[50][51]
Refractory CLL
"Refractory" CLL is a disease that no longer responds favorably to treatment. In this case, more aggressive therapies, including lenalidomide, flavopiridol, and bone marrow (stem cell) transplantation, are considered.[52] The monoclonal antibody alemtuzumab (directed against CD52) may be used in patients with refractory, bone marrow-based disease.[53]
During pregnancy
Leukemia is rarely associated with pregnancy, affecting only about one in 10,000 pregnant women.[54] Treatment for chronic lymphocytic leukemias can often be postponed until after the end of the pregnancy. If treatment is necessary, then giving chemotherapy during the second or third trimesters is less likely to result in pregnancy loss or birth defects than treatment during the first trimester.[54]
Prognosis
Prognosis depends on the subtype. Some subtypes have a median survival of 6–8 years, while others have a median survival of 22 years (which is a normal lifespan for older patients). Telomere length has been suggested to be a valuable prognostic indicator of survival.[55]
Epidemiology
CLL is primarily a disease of older adults, with a median age of 70 years at the time of diagnosis.[56] Though less common, CLL sometimes affects people between 30 and 39 years of age. The incidence of CLL increases very quickly with increasing age.
In the United States during 2014, about 15,720 new cases are expected to be diagnosed, and 4,600 patients are expected to die from CLL.[57] Because of the prolonged survival, which was typically about 10 years in past decades, but which can extend to a normal life expectancy,[27] the prevalence (number of people living with the disease) is much higher than the incidence (new diagnoses). CLL is the most common type of leukemia in the UK, accounting for 38% of all leukemia cases. Approximately 3,200 people were diagnosed with the disease in 2011.[58]
In Western populations, subclinical "disease" can be identified in 3.5% of normal adults,[59] and in up to 8% of individuals over the age of 70. That is, small clones of B cells with the characteristic CLL phenotype can be identified in many healthy elderly persons. The clinical significance of these cells is unknown.
In contrast, CLL is rare in Asian countries, such as Japan, China, and Korea, accounting for less than 10% of all leukemias in those regions.[28]: 1432 [56] A low incidence is seen in Japanese immigrants to the US, and in African and Asian immigrants to Israel.[28]
Of all cancers involving the same class of blood cell, 7% of cases are CLL/SLL.[60]
Rates of CLL are somewhat elevated in people exposed to certain chemicals. Under U.S. Department of Veterans' Affairs regulations, Vietnam veterans who served in-country or in the inland waterways of Vietnam and who later develop CLL are presumed to have contracted it from exposure to Agent Orange and may be entitled to compensation.
Research directions
Research in 2008 is comparing different forms of bone marrow transplants to determine which patients are the best candidates and which approach is best in different situations.[50]
| Wikinews has related news: |
Researchers at the Abramson Cancer Center of the University of Pennsylvania School of Medicine reported preliminary success in the use of gene therapy, through genetically modified T cells, to treat CLL.[61] The findings, which were published in August 2011,[62][63] were based on data from three patients who had modified T cells injected into their blood. The T cells had been modified to express genes that would allow the cells to proliferate in the body and destroy B cells including those causing the leukemia. Two patients went into remission, while the presence of leukemia in the third patient reduced by 70%.[64][65]
One of the patients had been diagnosed with CLL for 13 years, and his treatment was failing before he participated in the clinical trial. One week after the T cells were injected, the leukemia cells in his blood had disappeared.[66] The T cells were still found in the bloodstream of the patients six months after the procedure, meaning they would be able to fight the disease should leukemia cells return.[64] This was the first time scientists "have used gene therapy to successfully destroy cancer tumors in patients with advanced disease".[67]
Research is also investigating therapies targeting B cell receptor signalling. Syk inhibitor fostamatinib is in trials.[68] The trial of a combination of ibrutinib and venetoclax had encouraging results in a small number of people.[69]
See also
- Monoclonal B-cell lymphocytosis
- Virtual karyotype
- B-cell CLL/lymphoma
References
- ↑ O'Brien, Susan; Gribben, John G. (2008). Chronic Lymphocytic Leukemia. CRC Press. p. 19. ISBN 9781420068962. Archived from the original on 2017-12-22. Retrieved 2017-12-19.
- 1 2 3 4 5 6 7 8 9 10 "Chronic Lymphocytic Leukemia Treatment". National Cancer Institute. 26 October 2017. Archived from the original on 15 December 2017. Retrieved 19 December 2017.
- 1 2 3 4 5 "Chronic Lymphocytic Leukemia - Cancer Stat Facts". seer.cancer.gov. Archived from the original on 9 April 2018. Retrieved 20 December 2017.
- 1 2 3 4 5 6 7 8 9 Kipps, Thomas J.; Stevenson, Freda K.; Wu, Catherine J.; Croce, Carlo M.; Packham, Graham; Wierda, William G.; O'Brien, Susan; Gribben, John; Rai, Kanti (2017-01-19). "Chronic lymphocytic leukaemia". Nature Reviews Disease Primers. 3: 16096. doi:10.1038/nrdp.2016.96. ISSN 2056-676X. PMC 5336551. PMID 28102226.
- 1 2 3 4 5 Ferri, Fred F. (2017). Ferri's Clinical Advisor 2018 E-Book: 5 Books in 1. Elsevier Health Sciences. p. 750. ISBN 9780323529570. Archived from the original on 2020-06-30. Retrieved 2017-12-19.
- 1 2 GBD 2015 Disease and Injury Incidence and Prevalence, Collaborators. (8 October 2016). "Global, regional, and national incidence, prevalence, and years lived with disability for 310 diseases and injuries, 1990-2015: a systematic analysis for the Global Burden of Disease Study 2015". Lancet. 388 (10053): 1545–1602. doi:10.1016/S0140-6736(16)31678-6. PMC 5055577. PMID 27733282.
- 1 2 3 GBD 2015 Mortality and Causes of Death, Collaborators. (8 October 2016). "Global, regional, and national life expectancy, all-cause mortality, and cause-specific mortality for 249 causes of death, 1980-2015: a systematic analysis for the Global Burden of Disease Study 2015". Lancet. 388 (10053): 1459–1544. doi:10.1016/s0140-6736(16)31012-1. PMC 5388903. PMID 27733281.
- ↑ Boelens, J; Lust, S; Vanhoecke, B; Offner, F (February 2009). "Chronic lymphocytic leukaemia". Anticancer Research. 29 (2): 605–15. PMID 19331210.
- 1 2 3 4 5 6 Hallek, Michael; Shanafelt, Tait D; Eichhorst, Barbara (April 2018). "Chronic lymphocytic leukaemia". The Lancet. 391 (10129): 1524–1537. doi:10.1016/S0140-6736(18)30422-7. PMID 29477250.
- 1 2 3 4 "Chronic Lymphocytic Leukemia Treatment". National Cancer Institute. 1 January 1980. Archived from the original on 24 April 2015. Retrieved 19 February 2019.
- 1 2 Hallek, M (September 2017). "Chronic lymphocytic leukemia: 2017 update on diagnosis, risk stratification, and treatment". American Journal of Hematology. 92 (9): 946–965. doi:10.1002/ajh.24826. PMID 28782884.
- ↑ Jaffe ES (January 2019). "Diagnosis and classification of lymphoma: Impact of technical advances". Seminars in Hematology. 56 (1): 30–36. doi:10.1053/j.seminhematol.2018.05.007. PMID 30573042.
- ↑ Angelillo P, Capasso A, Ghia P, Scarfò L (December 2018). "Monoclonal B-cell lymphocytosis: Does the elderly patient need a specialistic approach?". European Journal of Internal Medicine. 58: 2–6. doi:10.1016/j.ejim.2018.09.006. PMID 30268574.
- ↑ Tresckow JV, Eichhorst B, Bahlo J, Hallek M (January 2019). "The Treatment of Chronic Lymphatic Leukemia". Deutsches Ärzteblatt International. 116 (4): 41–46. doi:10.3238/arztebl.2019.0041. PMC 6415618. PMID 30855005.
- ↑ Choi SM, O'Malley DP (December 2018). "Diagnostically relevant updates to the 2017 WHO classification of lymphoid neoplasms". Annals of Diagnostic Pathology. 37: 67–74. doi:10.1016/j.anndiagpath.2018.09.011. PMID 30308438.
- ↑ Hallek M (September 2017). "Chronic lymphocytic leukemia: 2017 update on diagnosis, risk stratification, and treatment". American Journal of Hematology. 92 (9): 946–965. doi:10.1002/ajh.24826. PMID 28782884.
- ↑ Tsimberidou AM, Keating MJ (January 2005). "Richter syndrome: biology, incidence, and therapeutic strategies". Cancer. 103 (2): 216–28. doi:10.1002/cncr.20773. PMID 15578683.
{{cite journal}}: CS1 maint: uses authors parameter (link) - ↑ Bitetto AM, Lamba G, Cadavid G, Shah D, Forlenza T, Rotatori F, Rafiyath SM. Colonic perforation secondary to chronic lymphocytic leukemia infiltration without Richter transformation. Leuk Lymphoma. 2011 May;52(5):930-3.
- 1 2 3 Strati, P; Jain, N; O'Brien, S (May 2018). "Chronic Lymphocytic Leukemia: Diagnosis and Treatment". Mayo Clinic Proceedings (Review). 93 (5): 651–64. doi:10.1016/j.mayocp.2018.03.002. PMID 29728204.
- ↑ Kipps, TJ; Stevenson, FK; Wu, CJ; Croce, CM; Packham, G; Wierda, WG; O'Brien, S; Gribben, J; Rai, K (19 January 2017). "Chronic lymphocytic leukaemia". Nature Reviews. Disease Primers. 3: 16096. doi:10.1038/nrdp.2016.96. PMC 5336551. PMID 28102226.
- ↑ Greer, John P.; Arber, Daniel A.; Glader, Bertil; List, Alan F.; Means Jr., Robert T.; Paraskevas, Frixos; Rodgers, George M.; Foerster, John, eds. (2014). Wintrobe's clinical hematology (Thirteenth ed.). Lippincott Williams & Wilkins. ISBN 978-1451172683.
- ↑ Bain, Barbara J. (2006). Blood Cells: A Practical Guide. Blackwell Publishing Limited. p. 439. ISBN 978-1-4051-4265-6.
- ↑ Matutes E, Owusu-Ankomah K, Morilla R, Garcia Marco J, Houlihan A, Que TH, Catovsky D (1994). "The immunological profile of B-cell disorders and proposal of a scoring system for the diagnosis of CLL". Leukemia. 8 (10): 1640–5. PMID 7523797.
{{cite journal}}: CS1 maint: uses authors parameter (link) - ↑ Deans JP, Polyak MJ (2008). "FMC7 is an epitope of CD20". Blood. 111 (4): 2492, author reply 2493–4. doi:10.1182/blood-2007-11-126243. PMID 18263793.
{{cite journal}}: CS1 maint: uses authors parameter (link) - ↑ Palumbo GA, Parrinello N, Fargione G, Cardillo K, Chiarenza A, Berretta S, Conticello C, Villari L, Di Raimondo F (2009). "CD200 expression may help in differential diagnosis between mantle cell lymphoma and B-cell chronic lymphocytic leukemia". Leuk. Res. 33 (9): 1212–6. doi:10.1016/j.leukres.2009.01.017. PMID 19230971.
{{cite journal}}: CS1 maint: uses authors parameter (link) - ↑ Zare H, Bashashati A, Kridel R, Aghaeepour N, Haffari G, Connors JM, Gascoyne RD, Gupta A, Brinkman RR, Weng AP (2012). "Automated analysis of multidimensional flow cytometry data improves diagnostic accuracy between mantle cell lymphoma and small lymphocytic lymphoma". Am. J. Clin. Pathol. 137 (1): 75–85. doi:10.1309/AJCPMMLQ67YOMGEW. PMC 4090220. PMID 22180480.
{{cite journal}}: CS1 maint: uses authors parameter (link) - 1 2 3 National Cancer Institute (January 1980). "Chronic Lymphocytic Leukemia (PDQ) Treatment: Stage Information". Archived from the original on 17 October 2007. Retrieved 2007-09-04.
- 1 2 3 4 5 Kaushansky, K; Lichtman, M; Beutler, E; Kipps, T; Prchal, J; Seligsohn, U. (2010). Williams Hematology (8th ed.). McGraw-Hill. ISBN 978-0071621519.
- ↑ Gale, Robert Peter; Rai, Kanti R., eds. (1987). Chronic lymphocytic leukemia : recent progress, future direction : proceedings of a Hyland Laboratories-UCLA symposium held in Napa, California, December 2–5, 1986. New York: Liss. ISBN 9780845126585.
- ↑ Rai KR, Sawitsky A, Cronkite EP, Chanana AD, Levy RN, Pasternack BS (Aug 1975). "Clinical staging of chronic lymphocytic leukemia". Blood. 46 (2): 219–34. doi:10.1182/blood.V46.2.219.219. PMID 1139039.
{{cite journal}}: CS1 maint: uses authors parameter (link) - ↑ Binet JL, Auquier A, Dighiero G, Chastang C, Piguet H, Goasguen J, Vaugier G, Potron G, Colona P, Oberling F, Thomas M, Tchernia G, Jacquillat C, Boivin P, Lesty C, Duault MT, Monconduit M, Belabbes S, Gremy F (Jul 1, 1981). "A new prognostic classification of chronic lymphocytic leukemia derived from a multivariate survival analysis". Cancer. 48 (1): 198–206. doi:10.1002/1097-0142(19810701)48:1<198::aid-cncr2820480131>3.0.co;2-v. PMID 7237385.
{{cite journal}}: CS1 maint: uses authors parameter (link) - ↑ Lehmann S, Ogawa S, Raynaud SD, Sanada M, Nannya Y, Ticchioni M, Bastard C, Kawamata N, Koeffler HP (March 2008). "Molecular allelokaryotyping of early-stage, untreated chronic lymphocytic leukemia". Cancer. 112 (6): 1296–305. doi:10.1002/cncr.23270. PMID 18246537.
{{cite journal}}: CS1 maint: uses authors parameter (link) - ↑ Sargent R, Jones D, Abruzzo LV, Yao H, Bonderover J, Cisneros M, Wierda WG, Keating MJ, Luthra R (January 2009). "Customized oligonucleotide array-based comparative genomic hybridization as a clinical assay for genomic profiling of chronic lymphocytic leukemia". J Mol Diagn. 11 (1): 25–34. doi:10.2353/jmoldx.2009.080037. PMC 2607562. PMID 19074592.
{{cite journal}}: CS1 maint: uses authors parameter (link) - ↑ Schwaenen C, Nessling M, Wessendorf S, Salvi T, Wrobel G, Radlwimmer B, Kestler HA, Haslinger C, Stilgenbauer S, Döhner H, Bentz M, Lichter P (January 2004). "Automated array-based genomic profiling in chronic lymphocytic leukemia: development of a clinical tool and discovery of recurrent genomic alterations". Proc. Natl. Acad. Sci. U.S.A. 101 (4): 1039–44. Bibcode:2004PNAS..101.1039S. doi:10.1073/pnas.0304717101. PMC 327147. PMID 14730057.
{{cite journal}}: CS1 maint: uses authors parameter (link) - ↑ Pfeifer D, Pantic M, Skatulla I, Rawluk J, Kreutz C, Martens UM, Fisch P, Timmer J, Veelken H (February 2007). "Genome-wide analysis of DNA copy number changes and LOH in CLL using high-density SNP arrays". Blood. 109 (3): 1202–10. doi:10.1182/blood-2006-07-034256. PMID 17053054.
{{cite journal}}: CS1 maint: uses authors parameter (link) - ↑ Gunn SR, Mohammed MS, Gorre ME, Cotter PD, Kim J, Bahler DW, Preobrazhensky SN, Higgins RA, Bolla AR, Ismail SH, de Jong D, Eldering E, van Oers MH, Mellink CH, Keating MJ, Schlette EJ, Abruzzo LV, Robetorye RS (September 2008). "Whole-genome scanning by array comparative genomic hybridization as a clinical tool for risk assessment in chronic lymphocytic leukemia". J Mol Diagn. 10 (5): 442–51. doi:10.2353/jmoldx.2008.080033. PMC 2518739. PMID 18687794.
{{cite journal}}: CS1 maint: uses authors parameter (link) - ↑ "T Cell Prolymphocytic Leukemia". AccessMedicine. Archived from the original on 2011-07-07. Retrieved 2009-02-04.
- ↑ Ascani S, Leoni P, Fraternali Orcioni G, Bearzi I, Piccioli M, Materazzi M, Zinzani PL, Gherlinzoni F, Falini B, Pileri SA (June 1999). "T-cell prolymphocytic leukaemia: does the expression of CD8+ phenotype justify the identification of a new subtype? Description of two cases and review of the literature". Ann. Oncol. 10 (6): 649–53. doi:10.1023/A:1008349422735. PMID 10442186.
{{cite journal}}: CS1 maint: uses authors parameter (link) - ↑ "Malignancies of Lymphoid Cells". Harrison's Principles of Internal Medicine (19 ed.). p. 695. ISBN 9780071802161.
- ↑ National Cancer Institute (January 1980). "Chronic Lymphocytic Leukemia (PDQ) Treatment: Stage I, II, III, and IV Chronic Lymphocytic Leukemia". Archived from the original on 17 October 2007. Retrieved 2007-09-04.
- ↑ Janssens; et al. (2011). "Rituximab for Chronic Lymphocytic Leukemia in Treatment-Naïve and Treatment-Experienced Patients". Contemporary Oncology. 3 (3): 24–36. Archived from the original on 2017-05-13. Retrieved 2012-01-23.
- ↑ Cheson BD, Bennett JM, Grever M, Kay N, Keating MJ, O'Brien S, Rai KR (1996). "National Cancer Institute-sponsored Working Group guidelines for chronic lymphocytic leukemia: revised guidelines for diagnosis and treatment". Blood. 87 (12): 4990–7. doi:10.1182/blood.V87.12.4990.bloodjournal87124990. PMID 8652811.
{{cite journal}}: CS1 maint: uses authors parameter (link) - ↑ Eichhorst BF, Busch R, Hopfinger G, Pasold R, Hensel M, Steinbrecher C, Siehl S, Jäger U, Bergmann M, Stilgenbauer S, Schweighofer C, Wendtner CM, Döhner H, Brittinger G, Emmerich B, Hallek M (2006). "Fludarabine plus cyclophosphamide versus fludarabine alone in first-line therapy of younger patients with chronic lymphocytic leukemia". Blood. 107 (3): 885–91. doi:10.1182/blood-2005-06-2395. PMID 16219797.
{{cite journal}}: CS1 maint: uses authors parameter (link) - ↑ Byrd JC, Peterson BL, Morrison VA, Park K, Jacobson R, Hoke E, Vardiman JW, Rai K, Schiffer CA, Larson RA (2003). "Randomized phase 2 study of fludarabine with concurrent versus sequential treatment with rituximab in symptomatic, untreated patients with B-cell chronic lymphocytic leukemia: results from Cancer and Leukemia Group B 9712 (CALGB 9712)". Blood. 101 (1): 6–14. doi:10.1182/blood-2002-04-1258. PMID 12393429.
{{cite journal}}: CS1 maint: uses authors parameter (link) - ↑ Keating MJ, O'Brien S, Albitar M, Lerner S, Plunkett W, Giles F, Andreeff M, Cortes J, Faderl S, Thomas D, Koller C, Wierda W, Detry MA, Lynn A, Kantarjian H (2005). "Early results of a chemoimmunotherapy regimen of fludarabine, cyclophosphamide, and rituximab as initial therapy for chronic lymphocytic leukemia". J. Clin. Oncol. 23 (18): 4079–88. doi:10.1200/JCO.2005.12.051. PMID 15767648.
{{cite journal}}: CS1 maint: uses authors parameter (link) - ↑ Rai KR, Peterson BL, Appelbaum FR, Kolitz J, Elias L, Shepherd L, Hines J, Threatte GA, Larson RA, Cheson BD, Schiffer CA (2000). "Fludarabine compared with chlorambucil as primary therapy for chronic lymphocytic leukemia". N. Engl. J. Med. 343 (24): 1750–7. doi:10.1056/NEJM200012143432402. PMID 11114313.
{{cite journal}}: CS1 maint: uses authors parameter (link) - ↑ Steurer M, Pall G, Richards S, Schwarzer G, Bohlius J, Greil R (2006). Steurer, Michael (ed.). "Purine antagonists for chronic lymphocytic leukaemia". Cochrane Database of Systematic Reviews. 3 (3): CD004270. doi:10.1002/14651858.CD004270.pub2. PMID 16856041.
{{cite journal}}: CS1 maint: uses authors parameter (link) - ↑ Hallek M, Fischer K, Fingerle-Rowson G, Fink AM, Busch R, Mayer J, Hensel M, Hopfinger G, Hess G, von Grünhagen U, Bergmann M, Catalano J, Zinzani PL, Caligaris-Cappio F, Seymour JF, Berrebi A, Jäger U, Cazin B, Trneny M, Westermann A, Wendtner CM, Eichhorst BF, Staib P, Bühler A, Winkler D, Zenz T, Böttcher S, Ritgen M, Mendila M, Kneba M, Döhner H, Stilgenbauer S (2010). "Addition of rituximab to fludarabine and cyclophosphamide in patients with chronic lymphocytic leukaemia: a randomised, open-label, phase 3 trial". Lancet. 376 (9747): 1164–74. doi:10.1016/S0140-6736(10)61381-5. PMID 20888994.
{{cite journal}}: CS1 maint: uses authors parameter (link) - ↑ Khan, M; Siddiqi, T (December 2018). "Targeted Therapies in CLL: Monotherapy Versus Combination Approaches". Current Hematologic Malignancy Reports. 13 (6): 525–533. doi:10.1007/s11899-018-0481-7. PMID 30535947.
- 1 2 Gribben JG (January 2008). "Stem cell transplantation in chronic lymphocytic leukemia". Biol. Blood Marrow Transplant. 15 (1 Suppl): 53–8. doi:10.1016/j.bbmt.2008.10.022. PMC 2668540. PMID 19147079.
{{cite journal}}: CS1 maint: uses authors parameter (link) - ↑ Dreger P, Brand R, Hansz J, Milligan D, Corradini P, Finke J, Deliliers GL, Martino R, Russell N, Van Biezen A, Michallet M, Niederwieser D (2003). "Treatment-related mortality and graft-versus-leukemia activity after allogeneic stem cell transplantation for chronic lymphocytic leukemia using intensity-reduced conditioning". Leukemia. 17 (5): 841–8. doi:10.1038/sj.leu.2402905. PMID 12750695.
{{cite journal}}: CS1 maint: uses authors parameter (link) - ↑ National Cancer Institute (January 1980). "Chronic Lymphocytic Leukemia (PDQ) Treatment: Refractory Chronic Lymphocytic Leukemia". Archived from the original on 17 October 2007. Retrieved 2007-09-04.
- ↑ Keating MJ, Flinn I, Jain V, Binet JL, Hillmen P, Byrd J, Albitar M, Brettman L, Santabarbara P, Wacker B, Rai KR (2002). "Therapeutic role of alemtuzumab (Campath-1H) in patients who have failed fludarabine: results of a large international study". Blood. 99 (10): 3554–61. doi:10.1182/blood.V99.10.3554. PMID 11986207.
{{cite journal}}: CS1 maint: uses authors parameter (link) - 1 2 Shapira T, Pereg D, Lishner M (September 2008). "How I treat acute and chronic leukemia in pregnancy". Blood Rev. 22 (5): 247–59. doi:10.1016/j.blre.2008.03.006. PMID 18472198.
{{cite journal}}: CS1 maint: uses authors parameter (link) - ↑ Rossi D, Lobetti Bodoni C, Genuardi E, Monitillo L, Drandi D, Cerri M, Deambrogi C, Ricca I, Rocci A, Ferrero S, Bernocco E, Capello D, De Paoli L, Bergui L, Boi M, Omedè P, Massaia M, Tarella C, Passera R, Boccadoro M, Gaidano G, Ladetto M (June 2009). "Telomere length is an independent predictor of survival, treatment requirement and Richter's syndrome transformation in chronic lymphocytic leukemia". Leukemia. 23 (6): 1062–72. doi:10.1038/leu.2008.399. hdl:2434/663837. PMID 19340005.
{{cite journal}}: CS1 maint: uses authors parameter (link) - 1 2 Shanshal M, Haddad RY (April 2012). "Chronic Lymphocytic Leukemia". Disease-a-Month. 58 (4): 153–167. doi:10.1016/j.disamonth.2012.01.009. PMID 22449365.
{{cite journal}}: CS1 maint: uses authors parameter (link) - ↑ National Cancer Institute (January 1980). "General Information About Chronic Lymphocytic Leukemia". Archived from the original on 2007-10-17. Retrieved 2007-09-04.
- ↑ "Chronic lymphocytic leukaemia (CLL) statistics". Cancer Research UK. Archived from the original on 12 May 2015. Retrieved 27 October 2014.
- ↑ Rawstron AC, Green MJ, Kuzmicki A, Kennedy B, Fenton JA, Evans PA, O'Connor SJ, Richards SJ, Morgan GJ, Jack AS, Hillmen P (July 2002). "Monoclonal B lymphocytes with the characteristics of "indolent" chronic lymphocytic leukemia are present in 3.5% of adults with normal blood counts". Blood. 100 (2): 635–9. doi:10.1182/blood.V100.2.635. PMID 12091358.
{{cite journal}}: CS1 maint: uses authors parameter (link) - ↑ Turgeon, Mary Louise (2005). Clinical hematology: theory and procedures. Hagerstown, MD: Lippincott Williams & Wilkins. p. 283. ISBN 978-0-7817-5007-3.
Frequency of lymphoid neoplasms. (Source: Modified from WHO Blue Book on Tumour of Hematopoietic and Lymphoid Tissues. 2001, p. 2001.)
{{cite book}}: CS1 maint: uses authors parameter (link) - ↑ Auer, Holly (August 10, 2011). "Genetically Modified "Serial Killer" T Cells Obliterate Tumors in Patients with Chronic Lymphocytic Leukemia, Penn Researchers Report". University of Pennsylvania School of Medicine. Archived from the original on October 18, 2016. Retrieved August 12, 2011.
- ↑ Porter DL, Levine BL, Kalos M, Bagg A, June CH (2011). "Chimeric Antigen Receptor–Modified T Cells in Chronic Lymphoid Leukemia". N. Engl. J. Med. 365 (8): 725–33. doi:10.1056/NEJMoa1103849. PMC 3387277. PMID 21830940.
{{cite journal}}: CS1 maint: uses authors parameter (link) - ↑ Kalos M, Levine BL, Porter DL, Katz S, Grupp SA, Bagg A, June CH (2011). "T Cells with Chimeric Antigen Receptors Have Potent Antitumor Effects and Can Establish Memory in Patients with Advanced Leukemia". Sci. Transl. Med. 3 (95): 95ra73. doi:10.1126/scitranslmed.3002842. PMC 3393096. PMID 21832238.
{{cite journal}}: CS1 maint: uses authors parameter (link) - 1 2 Palca, Joe (August 11, 2011). "Gene Therapy Advance Trains Immune System To Fight Leukemia". NPR. Archived from the original on August 13, 2011. Retrieved August 12, 2011.
- ↑ Bazell, Robert (August 10, 2011). "New leukemia treatment exceeds 'wildest expectations'". NBC News. Archived from the original on March 5, 2013. Retrieved August 12, 2011.
- ↑ DeNoon, Daniel J. (August 10, 2011). "Gene Therapy Cures Adult Leukemia". WebMD. Archived from the original on February 15, 2015. Retrieved August 12, 2011.
- ↑ Beasly, Deena (August 10, 2011). "Gene therapy shown to destroy leukemia tumors". Reuters. Archived from the original on September 24, 2015. Retrieved August 12, 2011.
- ↑ ten Hacken E, Burger JA (2014). "Microenvironment dependency in Chronic Lymphocytic Leukemia: The basis for new targeted therapies". Pharmacol. Ther. 144 (3): 338–48. doi:10.1016/j.pharmthera.2014.07.003. PMID 25050922.
{{cite journal}}: CS1 maint: uses authors parameter (link) - ↑ Forconi, Francesco; Fox, Christopher P.; Bloor, Adrian; Devereux, Stephen; Gribben, John G.; Pettitt, Andrew; Schuh, Anna; McCaig, Alison; MacDonald, Donald; Fegan, Christopher; Bishop, Rebecca; Yates, Francesca; Vicente, Samuel Munoz; Brock, Kristian; Rawstron, Andy; Munir, Talha; Hillmen, Peter (2017-12-07). "Initial Results of Ibrutinib Plus Venetoclax in Relapsed, Refractory CLL (Bloodwise TAP CLARITY Study): High Rates of Overall Response, Complete Remission and MRD Eradication after 6 Months of Combination Therapy". Blood. 130 (Suppl 1): 428. Archived from the original on 2018-07-30. Retrieved 2018-06-17.
External links
- Chronic Lymphocytic Leukemia Archived 2008-12-21 at the Wayback Machine at American Cancer Society
- General information about CLL Archived 2004-10-19 at the Wayback Machine from the US National Cancer Institute
- Cancer.Net: Chronic Lymphocytic Leukemia
| Classification | |
|---|---|
| External resources |
